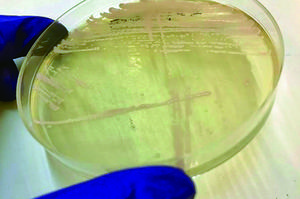

Más leídas

Actualidad | Pág. 2
Ministra de Transportes anuncia que la licitación del TMV será por tramos

Chile | Pág. 20
Visión de la FAO

Espectáculos | Pág. 42
El Farol abre sus puertas para recibir exposición colectiva de esculturas

Vida Social | Pág. 41
MBA de la Universidad Técnica Federico Santa María inaugura Año Académico en Valparaíso

Vida Social | Pág. 40
Claudio Grossman, Doctor Honoris Causa de la Universidad de Valparaíso

Vida Social | Pág. 39
Carozzi presentó tour virtual para que niños y jóvenes conozcan obra de Gaudí

Vida Social | Pág. 38
Deporte en el borde costero de Viña

Vida Social | Pág. 37
Desafíos de la regionalización y elección de gobernadores en Desayuno Análisis EMV-IST

Cartelera y Tv | Pág. 35
After: Aquí empieza todo

Deportes | Pág. 24
Colo Colo batalla para vencer a 0'Higgins con un agónico gol de Esteban Paredes

Deportes | Pág. 23
Juan Cuevas: "Quedamos con un sabor amargo"

Deportes | Pág. 22
"Si todos se unen tras la Corporación se podría recuperar a Wanderers"

Chile | Pág. 21
Star wars presenta su nuevo videojuego "jedi: fallen order"

Chile | Pág. 16
Rusia habla de un "fracaso" de la "guerra relámpago" de EE.UU. contra Nicolás Maduro

Actualidad | Pág. 3
Cruceros: cifras indican que se está revirtiendo negativo escenario

Chile | Pág. 15
Legisladores ingleses piden que Assange sea juzgado en Suecia

Chile | Pág. 14
Detectan en Chile presencia de un peligroso hongo resistente a los medicamentos

Chile | Pág. 13
Apertura de paso Pehuenche ayuda a Los Libertadores

Chile | Pág. 12
Ministra Cubillos: "Soy partidaria de avanzar hacia la educación mixta"

Opinión | Pág. 11
Gobernadora y municipio

Opinión | Pág. 10
El intendente y las universidades

Actualidad | Pág. 9
Los pequeños proyectos importan

Actualidad | Pág. 8
"Jamás se va a obtener algo que sea totalmente óptimo porque las condiciones van cambiando"

Actualidad | Pág. 7
Tatuador porteño deja su huella en el fútbol de Dubái

Actualidad | Pág. 6
Trabajadores de la educación superior en alerta por dictamen

Actualidad | Pág. 5
Contraloría constata irregular contrato de escritor en Cultura

Actualidad | Pág. 4
Exseminaristas confirman quiebre total con Ossandón y anuncian acciones legales

Espectáculos | Pág. 43
Javiera Mena habla de su participación en Coachella